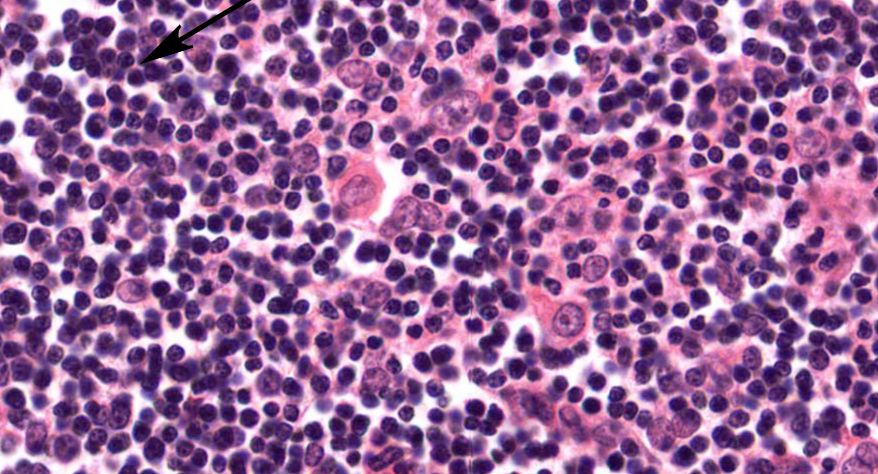
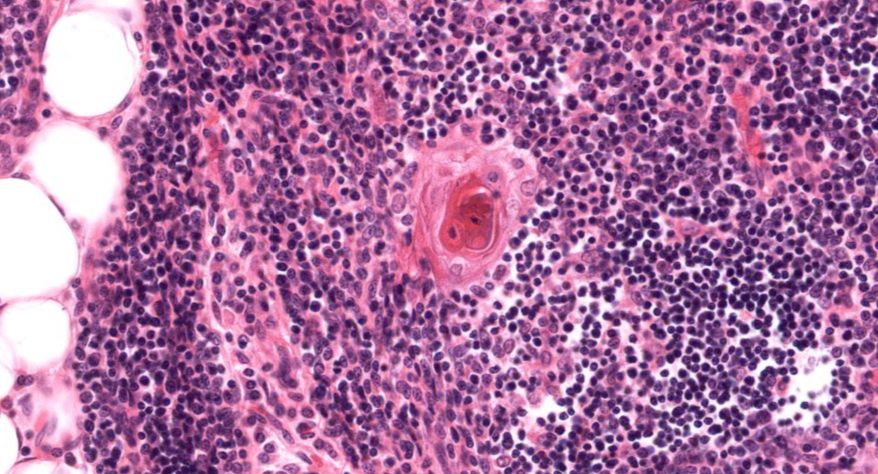
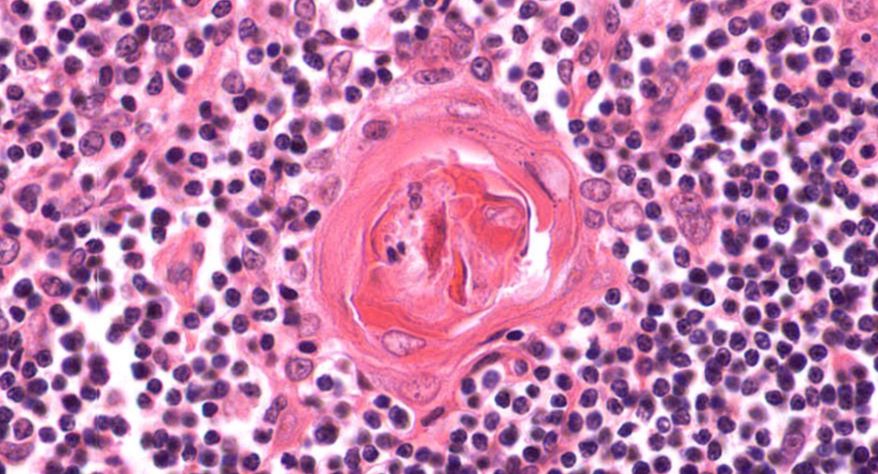
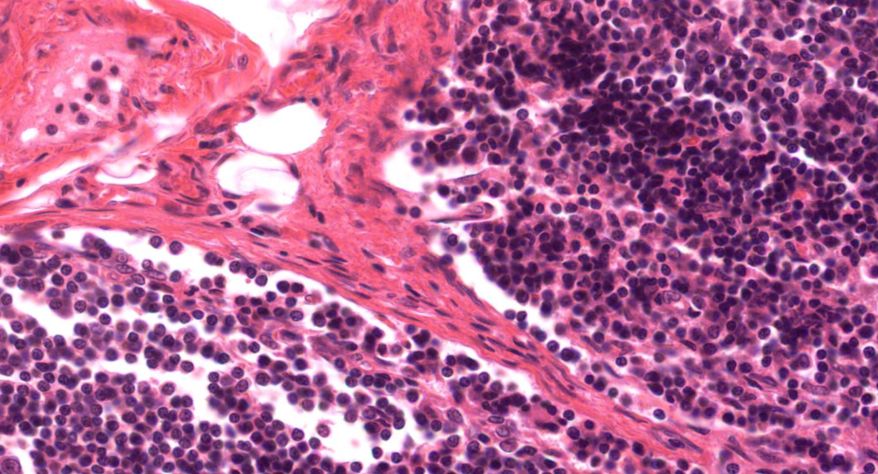
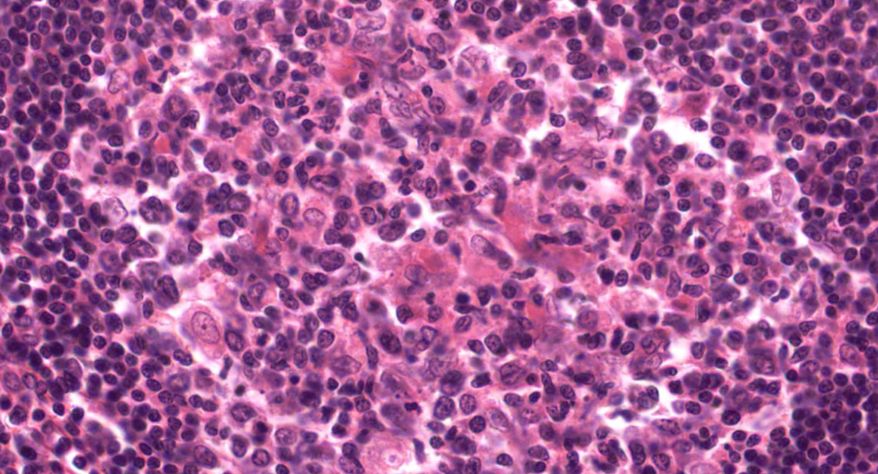
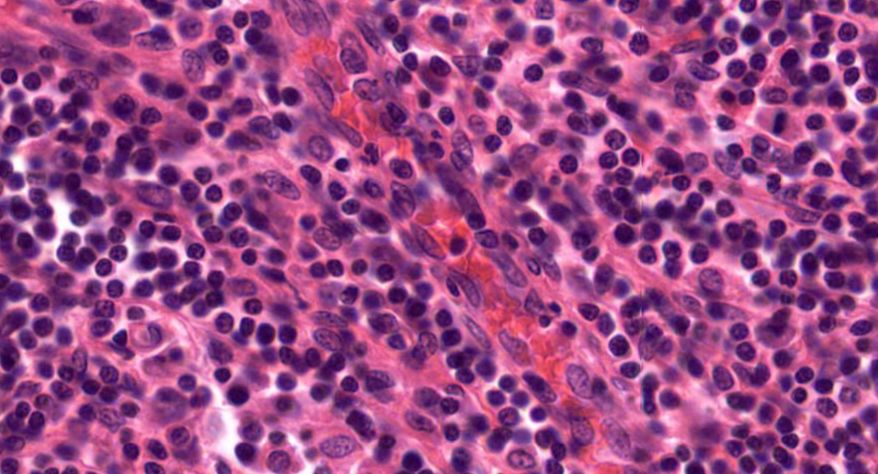
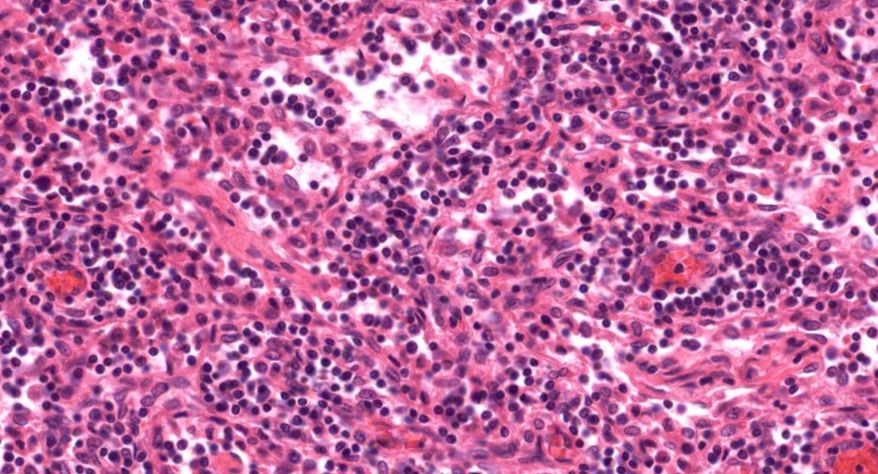
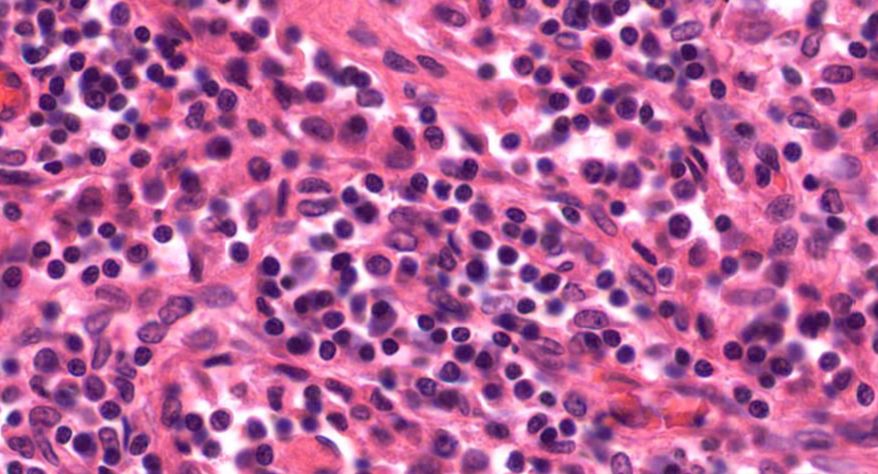
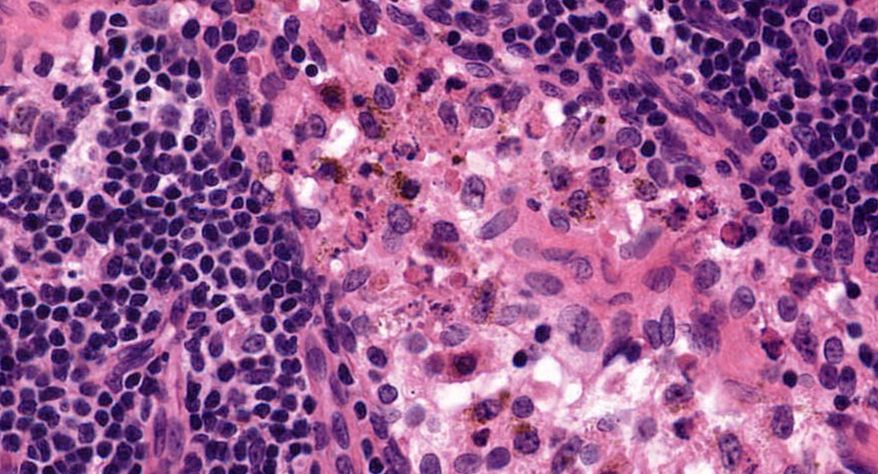
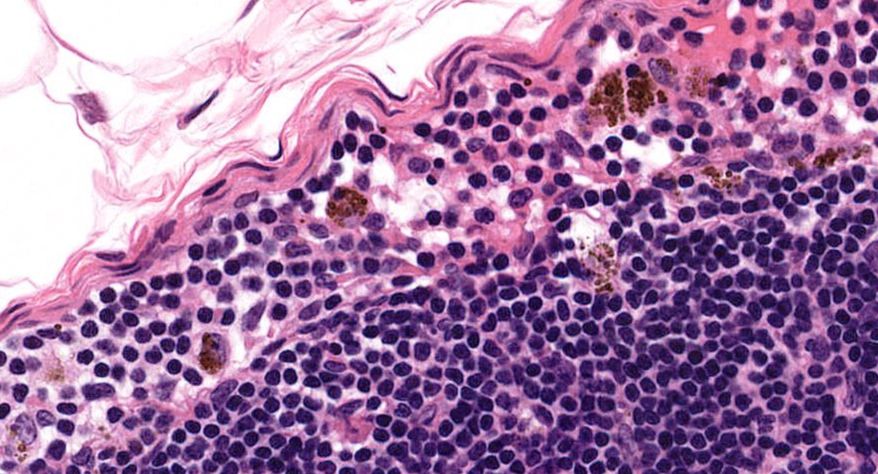
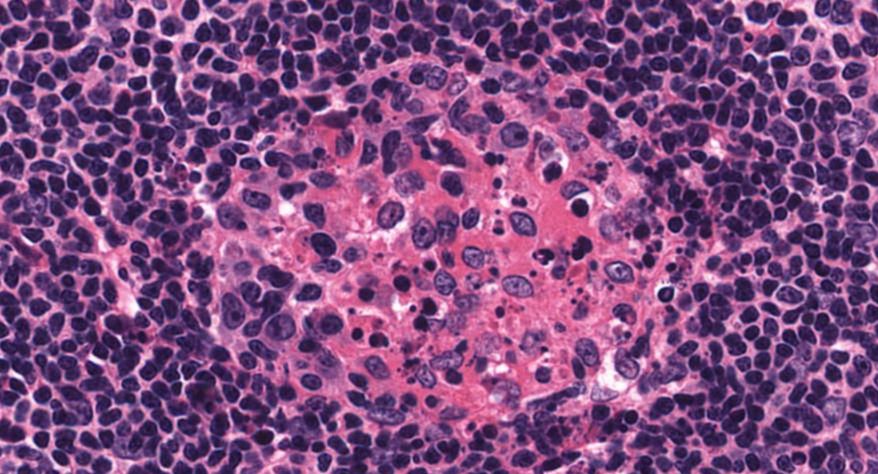
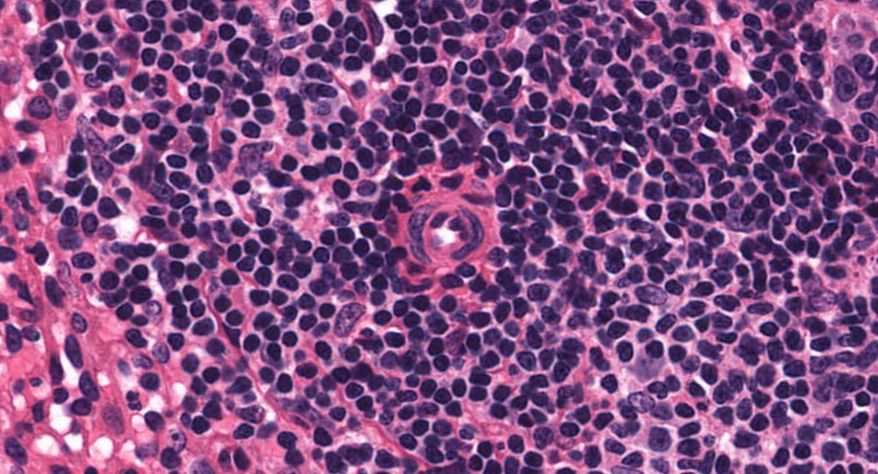
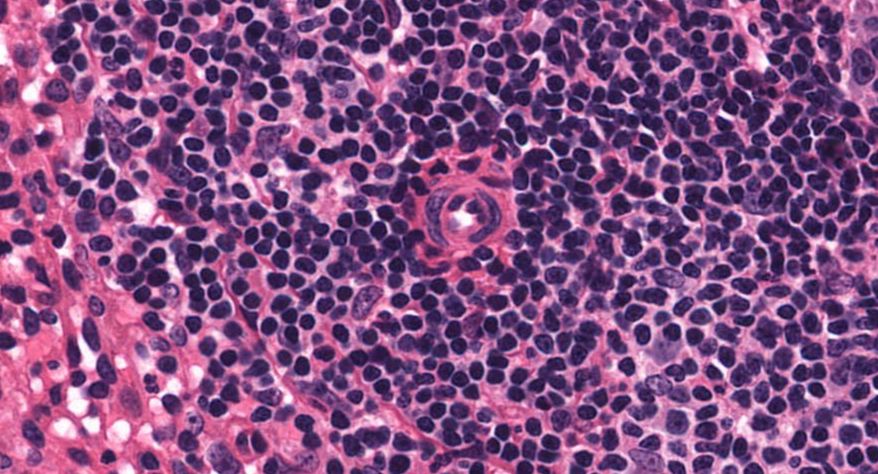
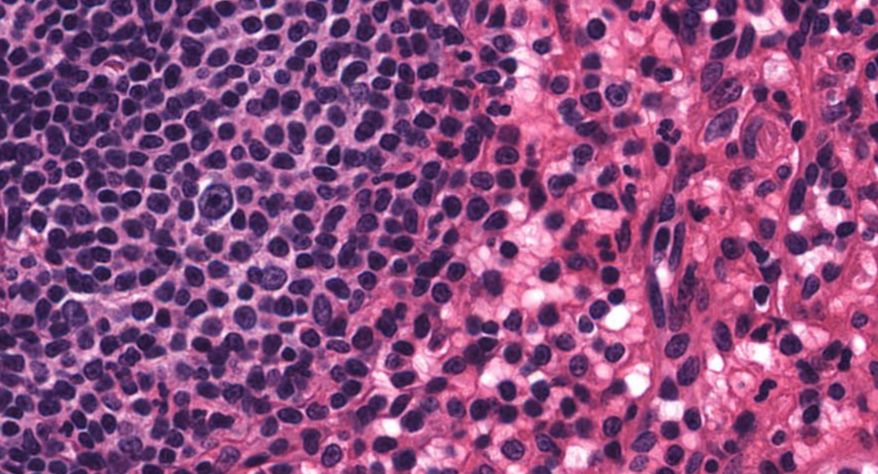
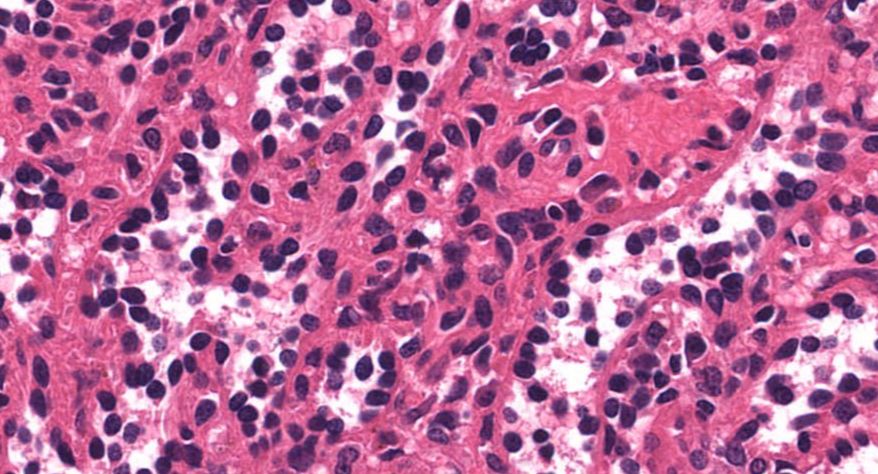
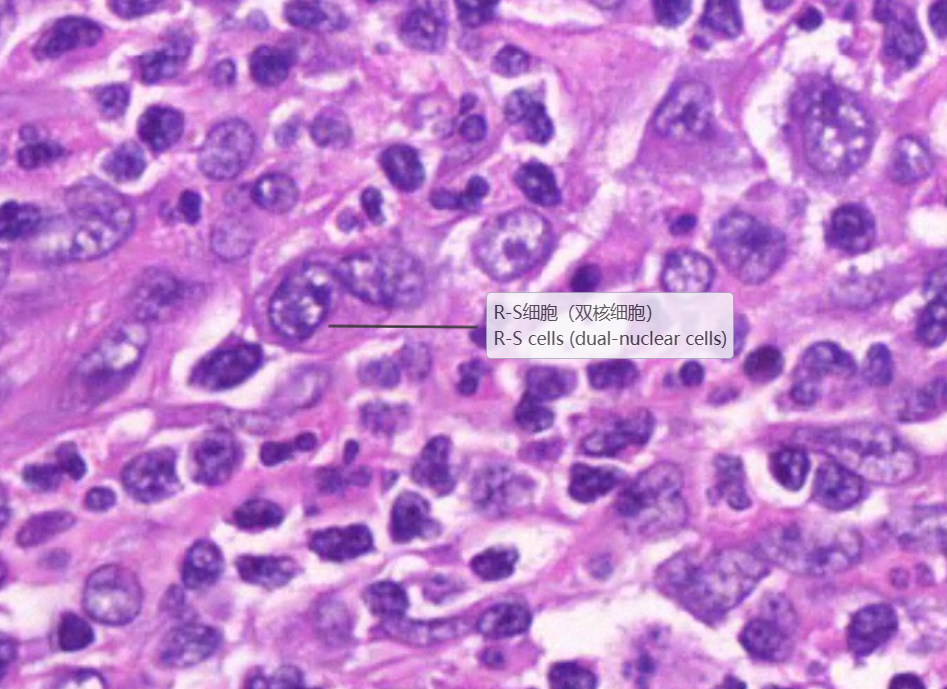

正常-病理对照图
-
1 胸腺
-
2 淋巴结
-
3 脾脏
-
4 霍奇金淋巴瘤
上一节
下一节
低倍镜:胸腺表面包有薄层结缔组织构成的被膜,结缔组织深入实质,将胸腺分成许多不完整的小叶。每个小叶分为周围的皮质和中央的髓质两部分。皮质中胸腺细胞排列密集,故染色深;髓质中胸腺细胞较少,胸腺上皮细胞多,故染色浅,其中可见染成红色的圆形小体-胸腺小体。高倍镜:胸腺小体大小不等,由几层至十几层扁平的胸腺上皮细胞呈同心圆状排列而成,其外周的细胞较幼稚,细胞核明显;小体中央部分的上皮细胞已退化,细胞核消失,胞质呈均质状,染成红色。
1.成人胸腺全景图

2.被膜

3.皮质

4.髓质

5.胸腺细胞

6.胸腺上皮细胞
7.胸腺小体1
8.胸腺小体2